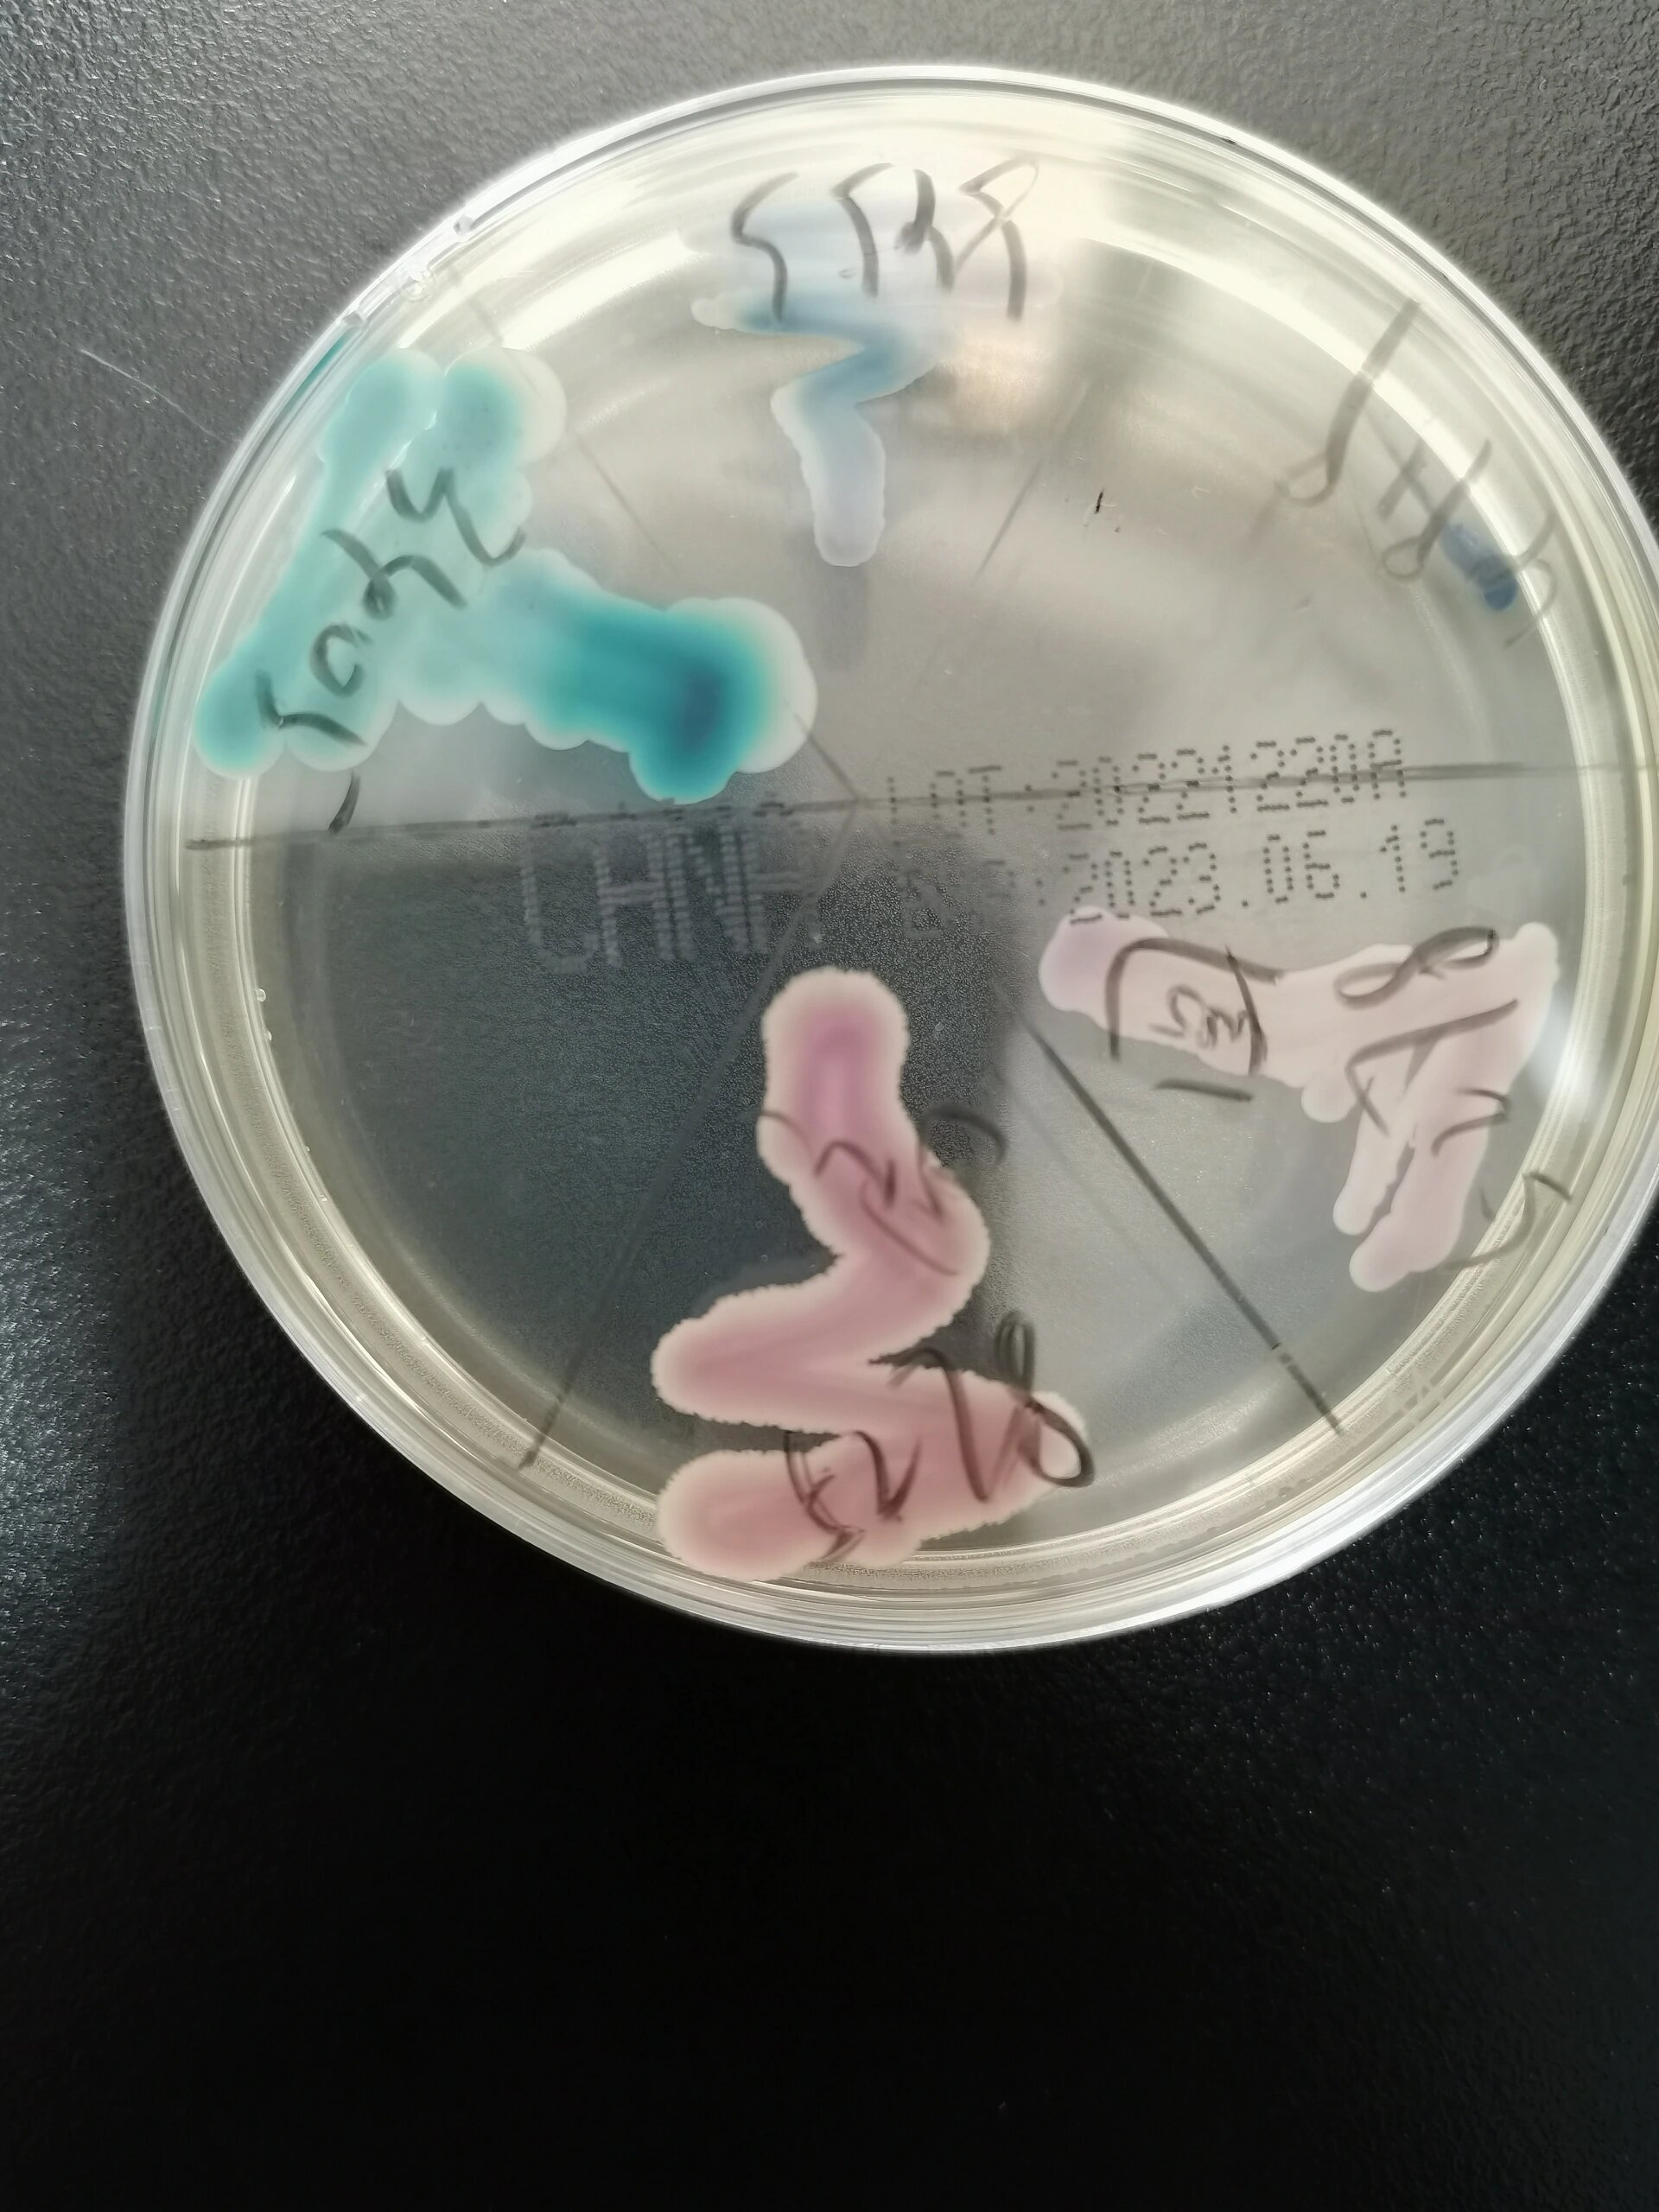
笔记22:克柔念珠菌吐温80玉米培养镜下形态 5278号,显色培养基显色为

克柔念珠菌百科

微生物之《克柔念珠菌》 克柔念珠菌:生长茂盛,菌落较大,模糊有微毛.
图片尺寸1280x1706
念珠菌是什么样子图片_生活常识_中睿百科网
图片尺寸491x311
【革兰染色显微镜下形态】其中翡翠样的绿色(白念珠菌)是罪魁祸首.
图片尺寸720x540
光滑与克柔氏念珠菌在念珠菌显色平板上的图片
图片尺寸2592x1944
克柔念珠菌的标记及抗克柔念珠菌对策
图片尺寸281x210
念珠菌病(念珠菌属引起的真菌病)摘编百科
图片尺寸650x416
五颜六色的念珠菌99 白色念珠菌,热带念珠菌,克柔念珠菌(也有点像
图片尺寸1280x1706
(菌落形态)充满朝气的绿色沉稳宁静的蓝色低调优雅的紫色温柔可爱的
图片尺寸720x728
【资源】念珠菌
图片尺寸446x360
几种真菌革兰染色图片镜下形态
图片尺寸1024x1154
光滑与克柔氏念珠菌在念珠菌显色平板上的图片
图片尺寸2592x1944
白色念珠菌,热带念珠菌,克柔念珠菌(也有点像光滑念珠菌)
图片尺寸1080x1439
ce 热带念珠菌d 光滑念珠菌c 白色念珠菌b 克柔念珠菌a 新型隐球菌
图片尺寸1080x1439
年首次美国检测到耳念珠菌
图片尺寸1024x1102
【革兰染色显微镜下形态】其中翡翠样的绿色(白念珠菌)是罪魁祸首.
图片尺寸720x540
外周血涂片中发现的热带念珠菌
图片尺寸533x545
白色念珠菌(a),克柔念珠菌(b),热带念珠菌(c)科马嘉培养基上菌落特征
图片尺寸542x482
白念珠菌_360百科
图片尺寸270x360
光滑与克柔氏念珠菌在念珠菌显色平板上的图片
图片尺寸339x419
笔记22:克柔念珠菌吐温80玉米培养镜下形态 5278号,显色培养基显色为
图片尺寸1920x2560